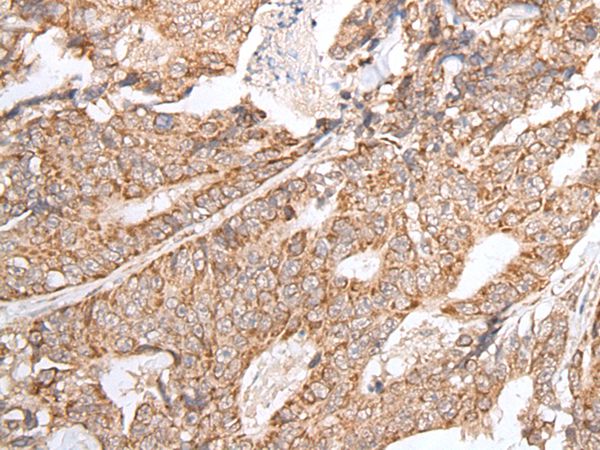
Anti-GNLY Antibody

granulysin (F-9) PE
SC-271119PE
ApplicationsFlow Cytometry, ImmunoFluorescence, Western Blot, ImmunoHistoChemistry, ImmunoHistoChemistry Paraffin
Product group Antibodies
ReactivityHuman
TargetGNLY
Overview
- SupplierSanta Cruz Biotechnology
- Product Namegranulysin (F-9) PE
- Delivery Days Customer5
- ApplicationsFlow Cytometry, ImmunoFluorescence, Western Blot, ImmunoHistoChemistry, ImmunoHistoChemistry Paraffin
- CertificationResearch Use Only
- ConjugateRPE
- Gene ID10578
- Target nameGNLY
- Target descriptiongranulysin
- Target synonymsD2S69E, LAG-2, LAG2, NKG5, TLA519, granulysin, T-cell activation protein 519, T-lymphocyte activation gene 519, lymphocyte-activation gene 2, lymphokine LAG-2
- HostMouse
- ReactivityHuman
- Storage Instruction2°C to 8°C
- UNSPSC12352203